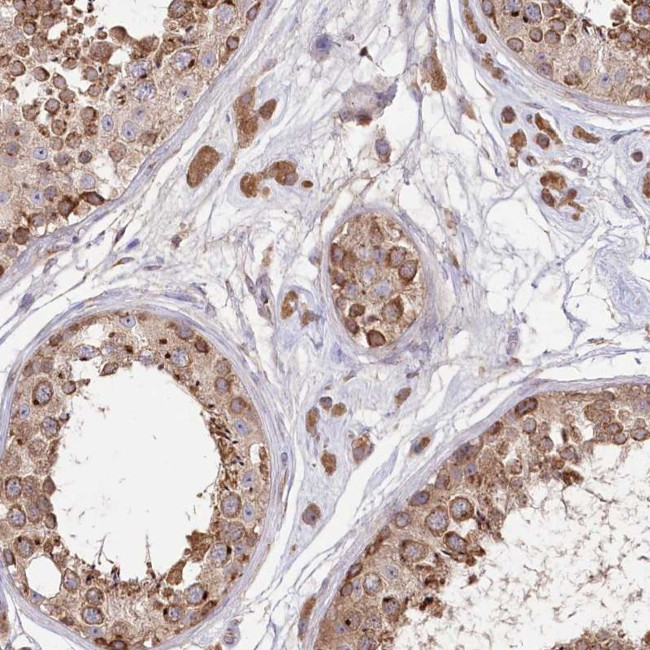
STT3B Antibody in Immunohistochemistry (Paraffin) (IHC (P))

Search
Invitrogen
STT3B Polyclonal Antibody
{{$productOrderCtrl.translations['antibody.pdp.commerceCard.promotion.promotions']}}
{{$productOrderCtrl.translations['antibody.pdp.commerceCard.promotion.viewpromo']}}
{{$productOrderCtrl.translations['antibody.pdp.commerceCard.promotion.promocode']}}: {{promo.promoCode}} {{promo.promoTitle}} {{promo.promoDescription}}. {{$productOrderCtrl.translations['antibody.pdp.commerceCard.promotion.learnmore']}}
产品信息
PA5-57663
种属反应
宿主/亚型
分类
类型
抗原
偶联物
形式
浓度
规格
纯化类型
保存液
内含物
保存条件
运输条件
RRID
产品详细信息
Immunogen sequence: KAPDNRETLD HKPRVTNIFP KQKYLSKKTT KRKRGYIK
Highest antigen sequence identity to the following orthologs: Mouse - 92%, Rat - 95%.
靶标信息
Catalytic subunit of the oligosaccharyl transferase (OST) complex that catalyzes the initial transfer of a defined glycan (Glc(3)Man(9)GlcNAc(2) in eukaryotes) from the lipid carrier dolichol-pyrophosphate to an asparagine residue within an Asn-X-Ser/Thr consensus motif in nascent polypeptide chains, the first step in protein N-glycosylation. N-glycosylation occurs cotranslationally and the complex associates with the Sec61 complex at the channel-forming translocon complex that mediates protein translocation across the endoplasmic reticulum (ER). All subunits are required for a maximal enzyme activity. This subunit contains the active site and the acceptor peptide and donor lipid-linked oligosaccharide (LLO) binding pockets. STT3B is present in a small subset of OST complexes and mediates both cotranslational and post-translational N-glycosylation of target proteins: STT3B-containing complexes are required for efficient post-translational glycosylation and while they are less competent than STT3A-containing complexes for cotranslational glycosylation, they have the ability to mediate glycosylation of some nascent sites that are not accessible for STT3A. STT3B-containing complexes also act post-translationally and mediate modification of skipped glycosylation sites in unfolded proteins. Plays a role in ER-associated degradation (ERAD) pathway that mediates ubiquitin-dependent degradation of misfolded endoplasmic reticulum proteins by mediating N-glycosylation of unfolded proteins, which are then recognized by the ERAD pathway and targeted for degradation. Mediates glycosylation of the disease variant AMYL-TTR 'Asp-38' of TTR at 'Asn-118', leading to its degradation.
仅用于科研。不用于诊断过程。未经明确授权不得转售。
篇参考文献 (0)
生物信息学
蛋白别名: dolichyl-diphosphooligosaccharide protein glycotransferase; Dolichyl-diphosphooligosaccharide--protein glycosyltransferase subunit STT3B; homolog of yeast STT3; Oligosaccharyl transferase subunit STT3B; Source of immunodominant MHC-associated peptides homolog; STT3, subunit of the oligosaccharyltransferase complex, homolog B; STT3B, catalytic subunit of the oligosaccharyltransferase complex; STT3B, subunit of the oligosaccharyltransferase complex (catalytic); unnamed protein product
基因别名: CDG1X; SIMP; STT3-B; STT3B
UniProt ID: (Human) Q8TCJ2
Entrez Gene ID: (Human) 201595